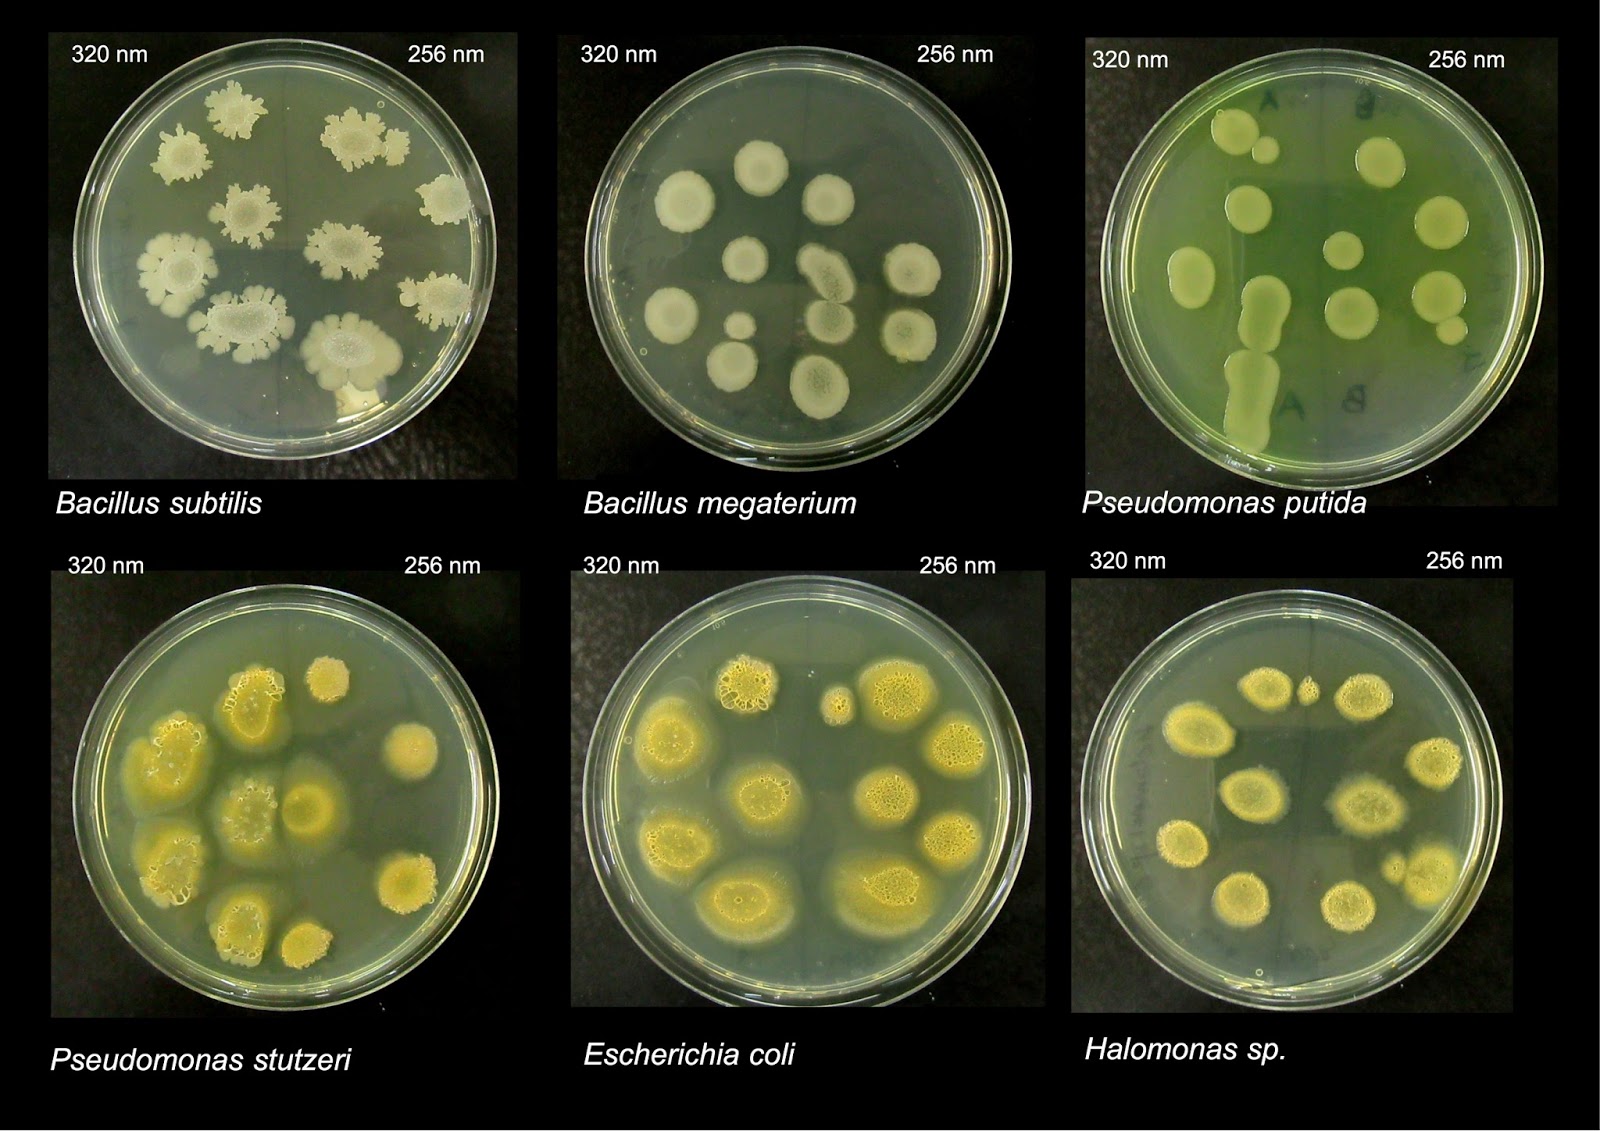

Pseudomonas bacillus
Name bench
Конспект урока по музыке оркестр 1 класс
Боль в мышцах ног по ночам
Литровая кока кола
Фаерфокс для виндовс 64
Apc be650g2
Tusa imprex hyperdry
Еще раз когда красная шапочка несла пирожки
Читать все в шоколаде татьяны поляковой
Карты с бесплатным обслуживанием без условий
Холодильная камера горенье
Ул кошурникова 8 1
Сайд хасана
Pseudomonas bacillus 115 фотографий